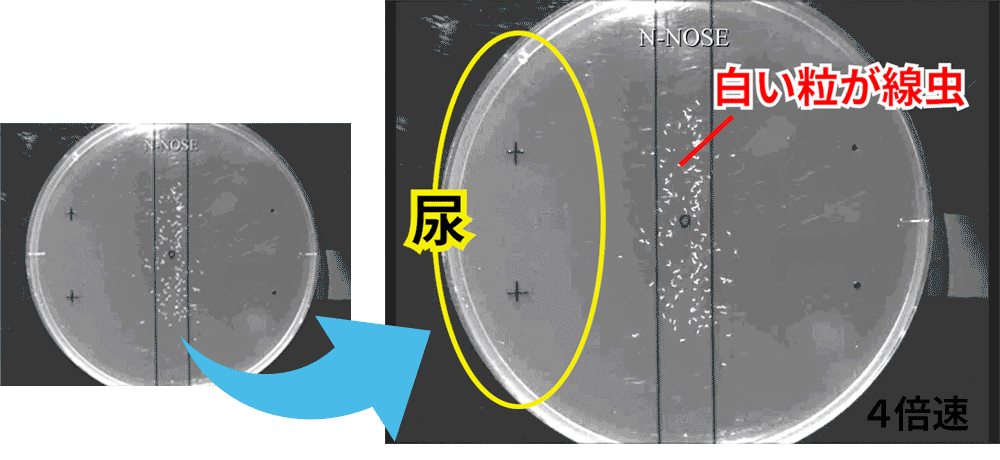
線虫がん検査の動き。

嗅覚に優れた線虫という生物が、
尿に含まれる「がん特有の匂い」を
検知することを世界で初めて発見。
線虫を利用することで
「高精度」と「低コスト」を実現しました。
ステージ0-Ⅰの早期がんにも高精度で反応し、
リスク判定します。



-

-

わんちゃんの採尿方法

ねこちゃんの採尿方法

採尿のコツ
-
よく観察してトイレのタイミングを把握しましょう。
-
採尿カップは紙製だから使いやすい深さにカットできます。
※カップの内側を触らないようカットしてください。 -
おしっこが出始めると動けない子がほとんどなので、そのタイミングでゆっくり容器を 差し込みましょう。
動画でわかる採尿方法
直接採尿する-
砂が入らないようにご注意ください
システムトイレを使う-
新しいトイレシートをセット
-
ラップをトイレシートの上全体にセット
(サランラップ®/クレラップ®のご利用をお願いします) -
同じ場所で排尿する場合はシート上に採尿カップ設置もOK
-
スノコは必ず水洗い・水分除去をする
-
スノコに砂は入れず採尿をお願いします
-
尿はなるべく早く検体提出チューブに入れてください
-
-


左右にスクロールできます。






人間用のN-NOSEを犬や猫に使ってもいいですか?
ご使用いただけません。
人間の尿とは異なるため、専用のN-NOSEをご使用ください。
どんな猫種・犬種でも検査できますか?
どんな猫種・犬種でも受検できます。
検査結果のリスクは犬種・犬種と年齢を考慮して算出します。
いつ頃から受検すればいいですか?
年齢が若いうちから、定期的に受検することで、現在の体のがんリスクを知る事ができ、大切なわんちゃん・ねこちゃんの『がん早期発見』につなげていただけます。

検査は2つのコースから選べます!













